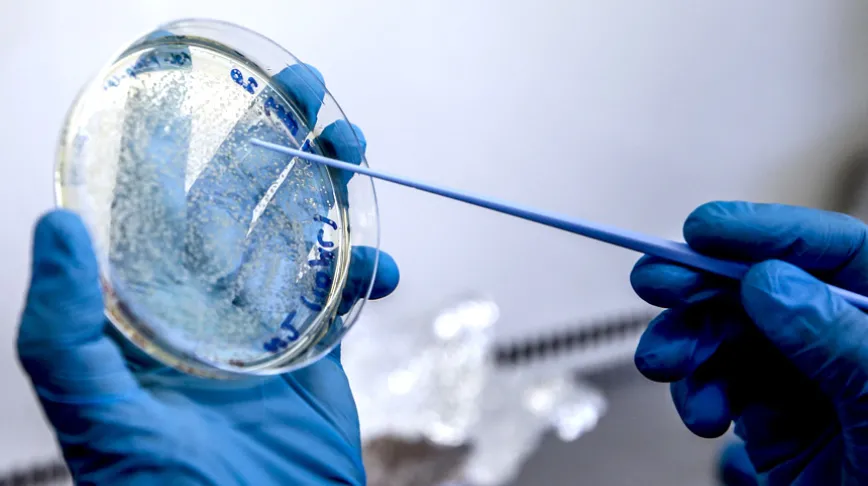
Baden-Württemberg eyaletinde bir çocukta maymun çiçeği virüsü görüldü

Haklı çıkmak için bu kadar düşmeyinArif Şentürk
Ali Yağız’ın başarısının sırrıArif Şentürk
Tavsiyelerimizi dikkate aldılarArif Şentürk
Ortak acıların son kullanma tarihi yokturArif Şentürk
Yakup OsmançelebioğluArif Şentürk
Aygül Özkan’ın ÇığlığıArif Şentürk
50. yıl vasiyetiArif Şentürk
Alışacaksınız, alışacaklar !Arif Şentürk
Çakallığın farkındayızArif Şentürk

Bayram Aybastı